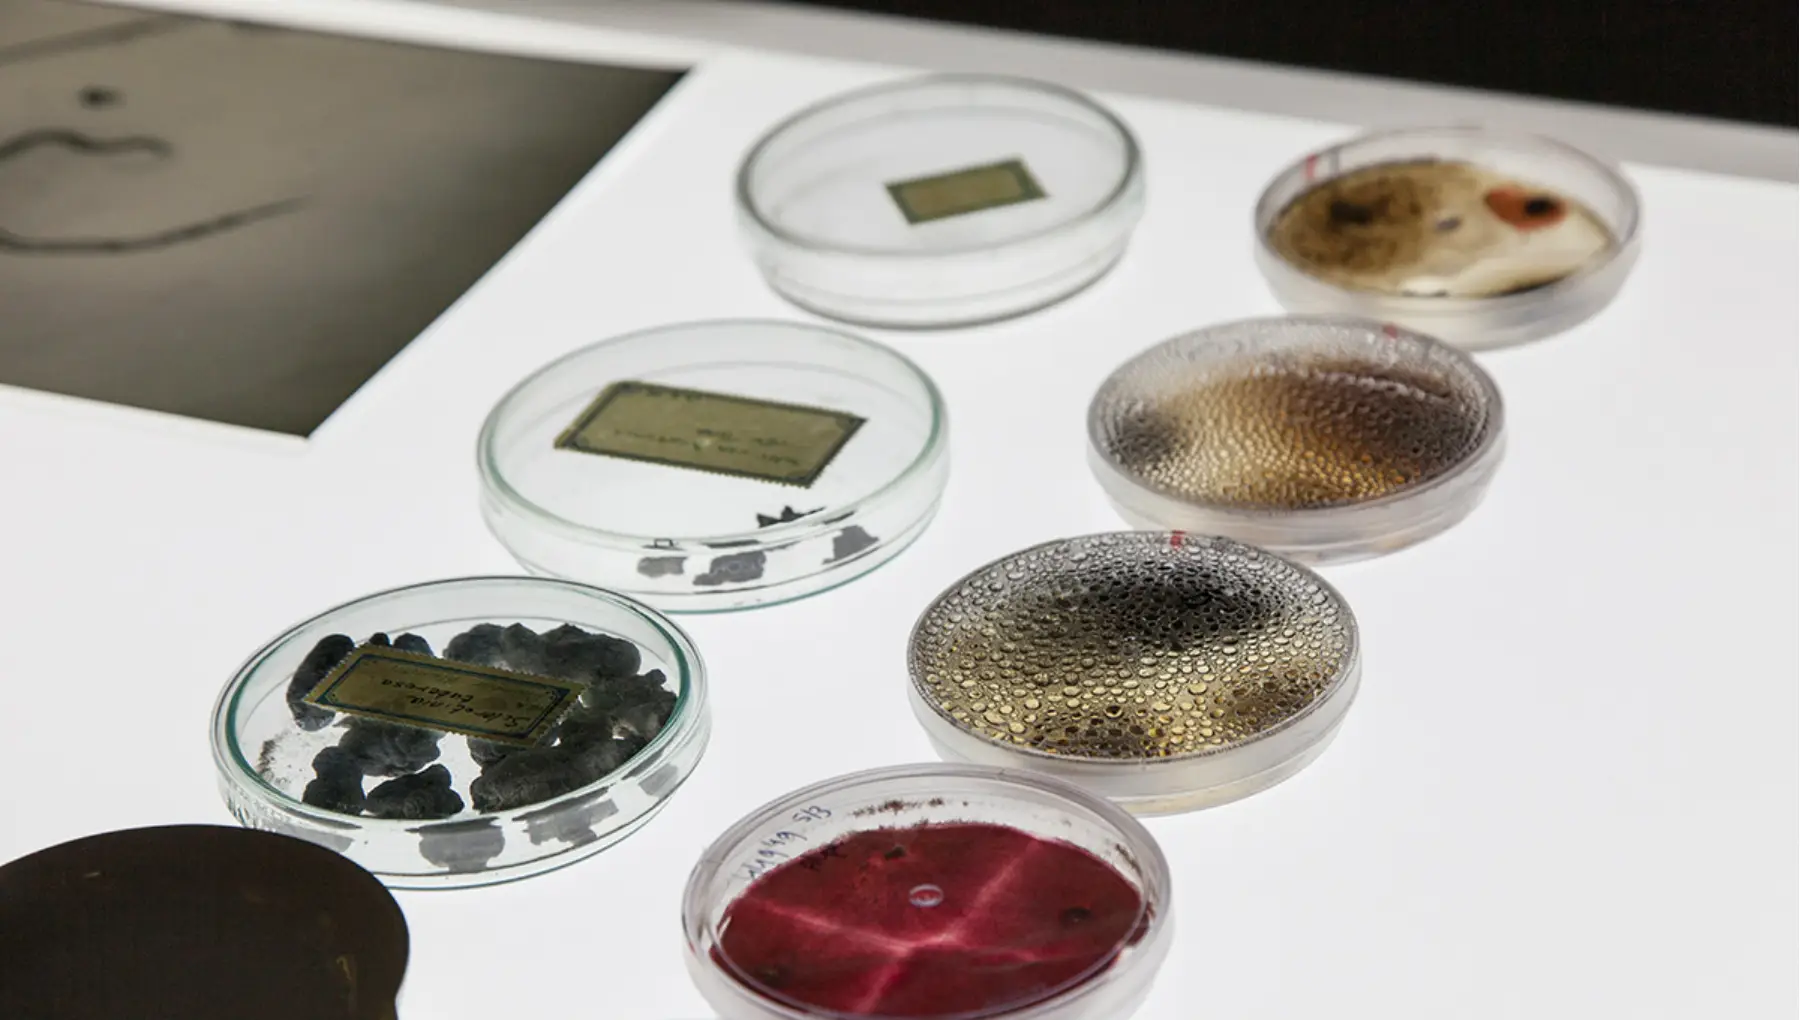

Museum De Zwarte Tulp

Museum De Zwarte Tulp, hét museum over de bloembollencultuur en -kunst, is gevestigd in Lisse, hart van de Bloembollenstreek.
Museum De Zwarte Tulp
Openingstijden
De schoonheid van bloemen
In het museum beleef je de Bloembollenstreek aan de hand van een interactieve tentoonstelling voor het hele gezin. Het museum vertelt over 500 jaar geschiedenis van de streek, de werkzaamheden op het land 100 jaar geleden en nu, en de wetenschap achter het ontwikkelen van nieuwe tulpensoorten.
Daarnaast kun je aan de hand van één van de belangrijkste prentencollecties op dit gebied, een kunstcollectie bestaande uit schilderijen, glas, zilver en porselein, en wisselende tentoonstellingen van hedendaagse kunst zien hoe kunstenaars telkens weer worden geïnspireerd door de schoonheid van bloemen.
Het museum is gehuisvest in een gebouw in het centrum van Lisse dat ooit als bollenschuur dienst deed. Onderdeel van het museum zijn de indrukwekkende vroeg 20e-eeuwse directiekamers van Kalkzandsteenfabriek Van Herwaarden BV – de Comparitie genaamd. In de museumtuin bloeit in het seizoen uiteraard een variatie aan bolgewassen.
Toegankelijkheid
Algemene voorzieningen en -informatie
Aanwezig, beschikbaar of toegestaan
- Lift
Voorzieningen voor mensen die minder mobiel zijn
Aanwezig, beschikbaar of toegestaan
- Rolstoeltoegankelijke entree
- Doorgangen voldoende breed
- Aangepast toilet
Voorzieningen voor mensen die blind of slechtziend zijn
Aanwezig, beschikbaar of toegestaan
- Beeldbeschrijving
Niet aanwezig, beschikbaar of toegestaan
- Assistentiehond toegestaan
- Persoonlijke assistent
- Geleidelijnen
- Lus voor slechthorende (vast of mobiel)
- Gebarentaalinterpretatie
- Gesloten ondertiteling
- Open ondertiteling
- Herkenning Sunflower-keycord
- Prikkelarme uren of voorstellingen
- Zintuiglijke beleving
- Toegankelijke informatie
- Materiaal in braille
- Trappen met leuning
- Mobiele pin















